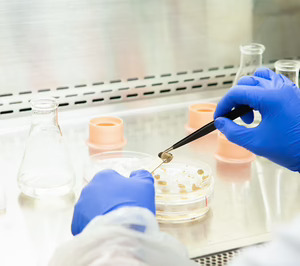
Pascual Innoventures se abre a nuevas áreas en la tercera edición de Mylkcubator

Pascual Innoventures, el vehículo de Corporate Venturing de Pascual, sigue avanzando en la investigación de los alimentos del futuro al ampliar su inversión hasta los 2 M€ en las tres primeras ediciones de "Mylkcubator", el programa de proyectos de innovación para el sector alimentario.
Bajo el lema "More than Mylk", la tercera edición del programa amplía su horizonte con áreas que incluyen los componentes del huevo, café, grasas y cacao, utilizando enfoques alternativos que combinan diversas tecnologías e ingredientes, así como el desarrollo de sustitutos de sodio y edulcorantes, como facilitadores tecnológicos; e ingredientes funcionales.
En concreto, ha realizado una inversión en la startup biotecnológica Onego Bio. Esta empresa estadounidense-finlandesa se dedica a la producción de una alternativa a la clara de huevo mediante fermentación de precisión. Un avance que permite evitar contaminaciones en la clara de huevo, crear productos veganos que contengan clara de huevo y reducir su impacto ambiental hasta en un 90%.
Dos startups españolas entran al programa
Otra novedad de la tercera edición de "Mylkcubator" es la elección de dos startups españolas: Cultzyme e Innomy, que lideran la biofabricación y la producción de proteínas alternativas.
La empresa bilbaína, Innomy, desarrolla soluciones globales para la industria alimentaria, utilizando procesos biotecnológicos sostenibles basados en micelio de hongos y revalorizando subproductos de diversas industrias como materias primas.
Por su parte, Cultzyme (San Sebastián) está centrada en bioprocesos de vanguardia, impulsando el progreso en el crecimiento celular y la fermentación. Sus innovadores y eficientes biorreactores integran el hardware más avanzado con IA y computación en la nube para acelerar el desarrollo de proteínas alternativas sostenibles.
Completan esta nueva edición la alemana Nosh.bio, especializada en la producción de nuevas proteínas funcionales y nutricionales a partir de la fermentación de biomasa de hongos naturales; y la estadounidense California Cultured, que desarrolla las tecnologías de cultivo de células vegetales más innovadoras para crear un nuevo suministro de chocolate y café que sea más escalable y sostenible para el planeta.
En palabras del CEO de Pascual Innoventures, Gabriel Torres Pascual, “el ecosistema foodtech de Mylkcubator ya ha generado un valor total de 280 M€ y ha recaudado 96 M€ en inversión, lo que pone de manifiesto el éxito y la relevancia del programa, que hemos impulsado junto a Eatable Adventures, en el panorama global de la innovación alimentaria”.